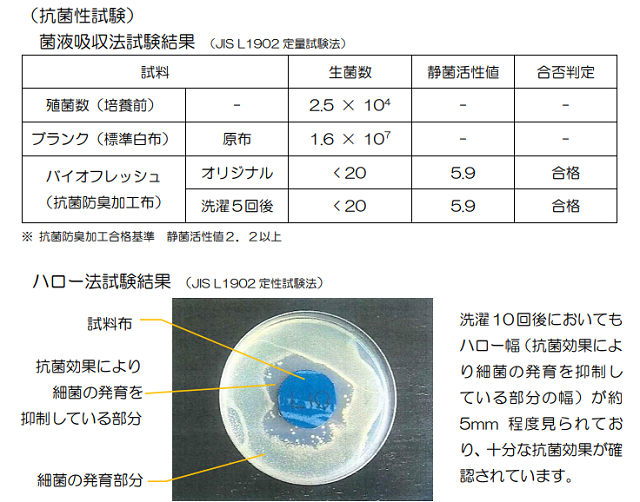

プロジェクト実行者
ストーリー
- 災害備蓄用の洗って何度も使える立体布マスク
- 抗菌・防臭加工の生地だから、より衛生的に♪
- 資金の一部は日本財団に寄付いたします!
自然災害の多い国 日本
日本は、外国に比べて台風、大雨、大雪、洪水、土砂災害、地震、津波、火山活動などの自然災害が発生しやすい国土です。加えて近年では異常気象や〇〇年に一度の大雨等による災害も増え、避難する機会が増えたように感じます。
もしもの時のために備えましょう!
「非常時持ち出し袋」準備していますか?
内容物は把握していますか?
マスクは足りていますか?
案外、非常時持ち出し袋に入っているマスクは少なかったりします。そこで弊社は何度も洗って使えるマスクを備えることをご提案させていただきます!

<画像提供:財団法人消防科学総合センター>
災害備蓄用マスク
今回ご提案させていただくマスクは災害備蓄用の布マスクです!長引くかもしれない避難生活時に何度も洗って使えるマスクは最適だと思い企画・発案いたしました。
それでは、このマスクの特徴についてご紹介させていただきます!

Point1 抗菌・防臭加工
今のご時世、あってほしいのは抗菌効果!SEK認証取得済みの「バイオフレッシュ加工」を施した生地を使用してます。抗菌効果により、生地に付着した細菌の繁殖を抑制します。また、洗濯耐久性に優れ、洗濯後の抗菌・防臭効果の低下が極めて少ないのも特徴です。経口・経皮毒性については、安全性の確認がとれた薬剤を使用しています。
Point2 フィットしやすい立体構造
皆様のお顔にしっかりとフィットしやすい立体構造の縫製にいたしました。鼻からアゴにかけて立体的に縫製することで、ご使用中の窮屈感も緩和できています。

Point3 Wガーゼを使用したサラッとした肌触り
マスク部分の生地は綿素材のWガーゼを使用しています。Wガーゼを二重になるように縫製し、程よい通気性とサラッとした肌触りで、長時間ご使用していただけます!
S/M/L のサイズ展開

安心安全の国内生産
生地の生産~縫製をすべて国内で行っております。梱包の際は弊社スタッフにより厳重なチェックの元おこなわれており、安心してご使用いただけます。

まだまだあります!嬉しいPoint
Point1 洗い替えできるように3枚セットに
ガーゼ素材なので乾きやすいですが、毎日ご使用いただけるように3枚1セットにしました!耐洗濯性の優れた抗菌加工を行っていますので、こまめに洗濯をし清潔にご使用いただけます。

Point2 アルミチャック袋で保管が可能!
耐光性に優れたアルミチャック袋に密封しています。未開封で長期保管にむいています。開封後はチャック仕様になっていますのでマスク袋としてもご利用いただけます!

Point3 予備のゴム 2本入り
万が一「ゴムヒモが切れた」や「抜けてなくしてしまった」という場合に備え、予備のゴムヒモを2本封入いたしております。ゴムヒモの通し口から細めの割りばし等で少しづつ押し込むように通して下さい。ゴムヒモの端に結び目を作ると通しやすいです。

スケジュール
本製品は2020年11月中旬頃~順次発送を予定しております。想定以上のご支援をいただいた場合は先着順で発送を行いますのでご了承ください。
資金の使い道
ご支援頂いたマスク1セットにつき100円を公益財団法人日本財団の「災害復興支援特別基金」に寄付させていただきます。被災地への緊急対応を即時実施するために活用されます。

<画像提供:財団法人消防科学総合センター>
また、残りの資金は原材料費と次回の製品開発費として活用させていただきます。
実行者紹介

弊社は「起毛総合メーカー」とし、あらゆる素材・組織の生地に「起毛加工」を行う会社です。生地の表面を針布でひっかき毛羽立たせることで保温性を上げるだけでなく、手触りをよくする、弾力をもたせる、摩擦を増やす等の様々な用途に合わせた起毛を行っています。

その「起毛」の技術を活かした製品を作ってみようと発足したのが「紀州ねる」です。紀州の職人が作った「ねる」グッズを開発・販売しています。
クラウドファンディングの実績
過去4回にわたるクアウドファンディングでの”ものづくり”では、多くのご支援や応援コメントに励ましていただき、完成させることができました。スタッフ一同大変うれしく思うとともに、さらなる良品の開発に精進していきたいと思う中、今回のプロジェクトにチャレンジしました。
クラウドファンディング第1弾 「超やわらか六重織ガーゼケット」

クラウドファンディング第2弾 「ボタニカル・ダイ 極上ブランケット」

クラウドファンディング第3弾 「ボタニカル・ダイ リバーシブルガーゼケット」

クラウドファンディング第4弾 「あったか起毛シーツ」

リターン紹介
完成した災害備蓄用マスクの3枚入りセットをご用意いたしました。
1セットのリターン 最大で25%OFF
2セットのリターン 最大で26%OFF
3セットのリターン 最大で27%OFF
5セットのリターン 28%OFF
10セットのリターン 29%OFF
50セットのリターン 31%OFF
※税込・送料込の価格で表記いたしております
なお、10セットと50セットのリターンにつきましてはサイズを1種類ご選択いただきますがご了承ください。2~5セットにつきましては複数のサイズをご選びいただけます。
最後に
最後までご覧いただき、誠にありがとうございました。
繊維業界は衰退し職人が次々に引退していく中、弊社では次の世代にも起毛業を持続するために若い職人の育成に力をいれています。また、様々な分野のテキスタイルへの起毛加工に挑戦することや、起毛技術の発信にも力を入れており、クラウドファンディングを通して「起毛」を知ってもらえればと思っています。

今回のマスクでは起毛加工を行っていませんが、繊維の知識を活かした製品に仕上がっています。今後の製品開発にも活きる試みでありました(縫製等)。「紀州ねる」の次回作にも期待していただければ幸いです。
紀州ねる 店長 島本和典

リスク&チャレンジ
※本プロジェクトを通して想定を上回る皆様からご支援を頂き、現在進めている環境から量産体制を更に整えることができた場合、正規販売価格が販売予定価格より下がる可能性もございます。 ※開発中の製品につきましては、デザイン・仕様が一部変更になる可能性もございます。 ※ご注文状況、使用部材の供給状況、製造工程上の都合等により出荷時期が遅れる場合があります。
サポーターからの応援コメント
文章のトップに戻る
応援購入する
このプロジェクトはAll in型です。目標金額の達成に関わらず、プロジェクト終了日の2020年10月30日までに支払いを完了した時点で購入が成立します。
【超早割25%OFF】備蓄用 立体マスク 3枚入り1セット

3,375円(税込)
【先着100名様!】
抗菌防臭加工
備蓄用 立体ガーゼマスク
3枚入り1セット
S・M・Lサイズからお選びいただけます
(送料・税込価格)
※Makuake限定 販売予定価格25%OFF
【早割20%OFF】備蓄用 立体マスク 3枚入り1セット

3,600円(税込)
【先着200名様!】
抗菌防臭加工
備蓄用 立体ガーゼマスク
3枚入り1セット
S・M・Lサイズからお選びいただけます
(送料・税込価格)
※Makuake限定 販売予定価格20%OFF
【Makuake限定価格15%OFF】備蓄用 立体マスク 3枚入り1セット

3,825円(税込)
抗菌防臭加工
備蓄用 立体ガーゼマスク
3枚入り1セット
S・M・Lサイズからお選びいただけます
(送料・税込価格)
※Makuake限定 販売予定価格15%OFF
【超早割26%OFF】備蓄用 立体マスク 2セット3枚入り

6,660円(税込)
【先着50名様!】
抗菌防臭加工
備蓄用 立体ガーゼマスク
3枚入り2セット
S・M・Lサイズからご自由にお選びいただけます
(送料・税込価格)
※Makuake限定 販売予定価格26%OFF
【早割21%OFF】備蓄用 立体マスク 2セット3枚入り

7,110円(税込)
【先着50名様!】
抗菌防臭加工
備蓄用 立体ガーゼマスク
3枚入り2セット
S・M・Lサイズからご自由にお選びいただけます
(送料・税込価格)
※Makuake限定 販売予定価格21%OFF
【超早割27%OFF】備蓄用 立体マスク 3セット 3枚入り

9,855円(税込)
【先着50名様!】
抗菌防臭加工
備蓄用 立体ガーゼマスク
3枚入り3セット
S・M・Lサイズからご自由にお選びいただけます
(送料・税込価格)
※Makuake限定 販売予定価格27%OFF
【超早割28%OFF】備蓄用 立体マスク 5セット 3枚入り

16,200円(税込)
【先着20名様!】
抗菌防臭加工
備蓄用 立体ガーゼマスク
3枚入り5セット
S・M・Lサイズからご自由にお選びいただけます
(送料・税込価格)
※Makuake限定 販売予定価格28%OFF
【まとめ割29%OFF】備蓄用 立体マスク 10セット 3枚入り

31,950円(税込)
【先着50名様!】
抗菌防臭加工
備蓄用 立体ガーゼマスク
3枚入り10セット
S・M・Lサイズから1サイズお選びいただけます
(送料・税込価格)
※Makuake限定 販売予定価格29%OFF
【まとめ割31%OFF】備蓄用 立体マスク 50セット 3枚入り

155,250円(税込)
抗菌防臭加工
備蓄用 立体ガーゼマスク
3枚入り50セット
S・M・Lサイズから1サイズお選びいただけます
(送料・税込価格)
※Makuake限定 販売予定価格31%OFF
「Makuake(マクアケ)」は、実行者の想いを応援購入によって実現するアタラシイものやサービスのプラットフォームです。このページは、 プロダクトカテゴリの 「もしもに備えておこう!繰り返し使える抗菌防臭機能付きダブルガーゼマスク」プロジェクト詳細ページです。
